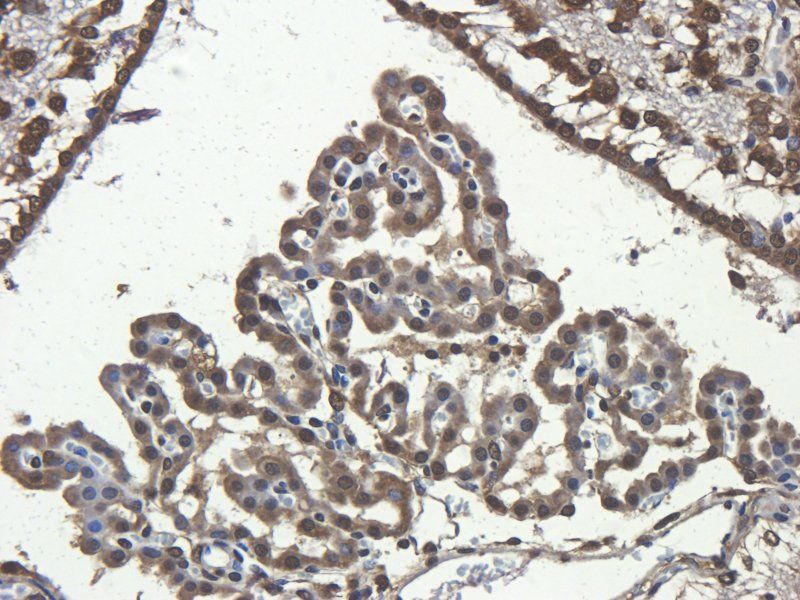
产品细节图片1
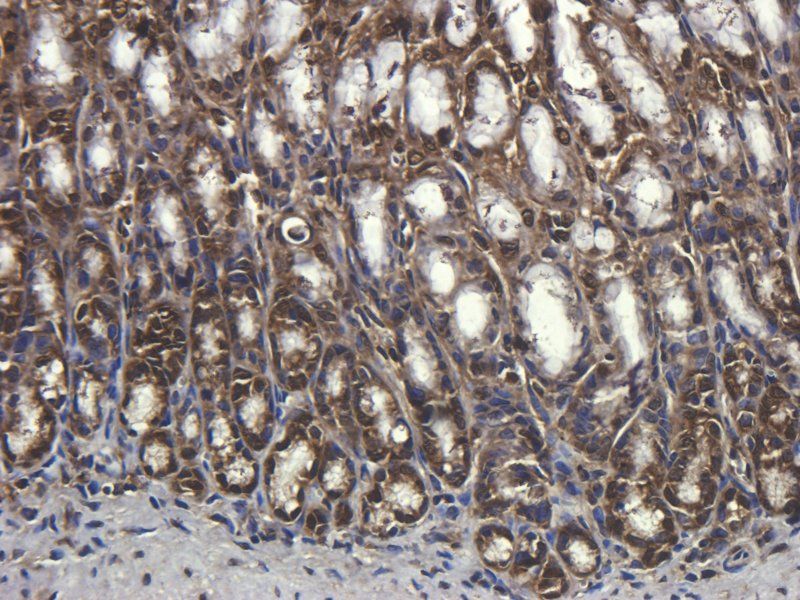
产品细节图片2
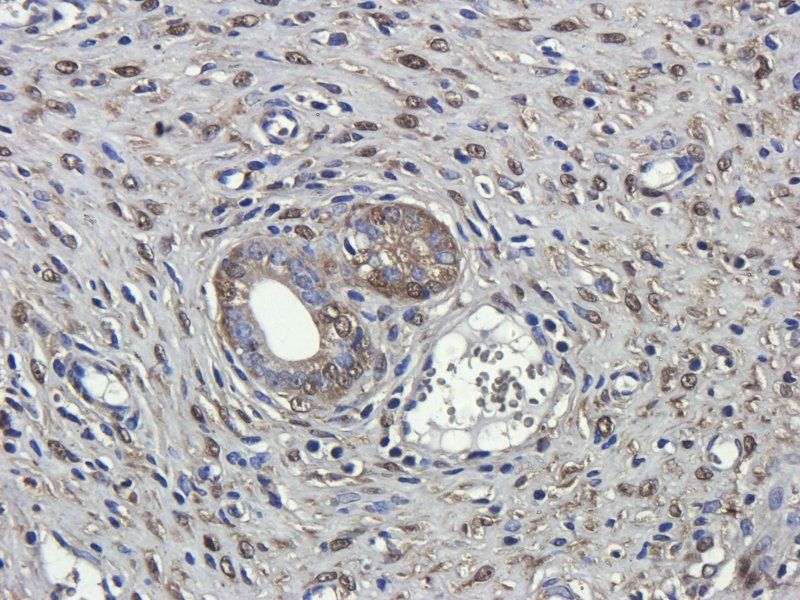
产品细节图片3
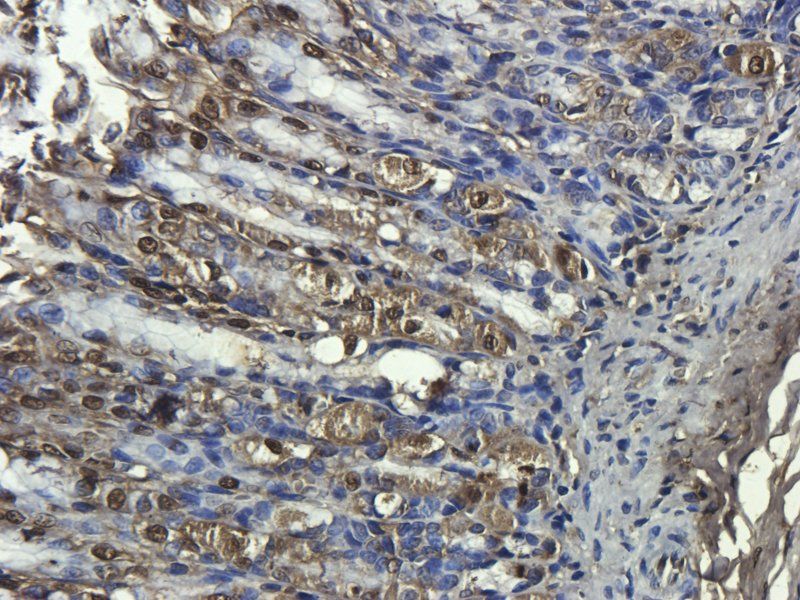
产品细节图片9

相关产品推荐更多 >
万千商家帮你免费找货
0 人在求购买到急需产品
- 详细信息
- 文献和实验
- 技术资料
- 抗体名:
CD68 antibody抗体
- 抗体英文名:
CD68 antibody
- 靶点:
CD68
- 浓度:
- 100 μg (in 200 μl): 0.5 mg/ml- 200 μg (in 400 μl): 0.5 mg/ml
- 应用范围:
IHC-P, WB
- 宿主:
Rabbit
- 适应物种:
Human, Mouse, Rat
- 保质期:
6-12个月
- 抗原来源:
详询
- 目录编号:
orb10343
- 级别:
科研级
- 库存:
88
- 供应商:
biorbyt
- 标记物:
Unconjugated
- 克隆性:
Polyclonal
- 形态:
10 mM PBS, 0.02% sodium azide
- 亚型:
IgG
- 免疫原:
KLH conjugated synthetic peptide derived from human CD68. Please contact us for the exact immunogen sequence. The peptide is available as orb374715.
- 规格:
100 ug
别名:anti-CD68 antibody, anti-CD68gen antibody, anti-CD68 molecule antibody, anti-DKFZp686M18236 antibody, anti-GP110 antibody, anti-Macrophagegen CD68 (microsialin) antibody, anti-macrosialin antibody, anti-SCARD1 antibody, anti-Scavenger receptor class D member 1 antibody
免疫原:KLH conjugated synthetic peptide derived from human CD68. Please contact us for the exact 免疫原 sequence. The peptide is available as orb374715.
分子量:37 kDa
应用稀释比例:WB:1:100-2000, IHC-P:1:100-1000 (based on 0.5 mg/ml)
纯度:Polyclonal antibodies are purified by peptide affinity chromatography
保存说明:Maintain refrigerated at 2-8°C for up to 2 weeks. For long term storage store at -20°C in small aliquots to prevent freeze-thaw cycles.
NCBI:11, 033983, 009853
Entrez:12514
UniProt ID:P31996, Q4FZY1
Note:For research use only.

风险提示:丁香通仅作为第三方平台,为商家信息发布提供平台空间。用户咨询产品时请注意保护个人信息及财产安全,合理判断,谨慎选购商品,商家和用户对交易行为负责。对于医疗器械类产品,请先查证核实企业经营资质和医疗器械产品注册证情况。
文献和实验CD68 分子 CD68 常用单克隆抗体或代号: EBM11,Ki- M7,Ki- M6 主要表达细胞: Mac,Ptac [M] 分子质量(kDa)和结构: gp110 功 能: 参与细胞摄粒作用和溶酶体运输 CD68 Aka KP-1 May have role in macrophage phagocytic activities Specific to lysosomes, not cell
15 秒止血!MIT 赵选贺团队受自然启发,研制出如此神奇的
心肌细胞的体外细胞毒性与对照组相当;通过背侧皮下移植来评估膏体的体内生物相容性,组织学评估结果表明,藤壶胶样的生物粘合剂引发了非常轻微的炎症,与 FDA 已经批准的组织粘合剂 CoSeal 相当。图片来源:Nat Biomed Eng为了进一步研究藤壶胶样的膏状物的体内生物相容性,他们对成纤维细胞的多种标记物,如 α-平滑肌肌动蛋白(αSMA)、I 型胶原以及与炎症反应相关的 T 细胞(CD3)和巨噬细胞(CD68)进行免疫荧光强度分析。结果发现,藤壶胶样的生物粘合剂在各时间点的 αSMA、I 型胶原、CD
Nature Medicine 再论多重免疫荧光揭示预测性生物标志物,用于优化免疫治疗临床试验设计
同时检测(1)细胞毒性 T 细胞(CD8 和自然杀伤细胞)、Treg 细胞(CD8+、GzmA+ 、CD4+、FOXP3+/CD56+)(2) B 细胞、PC 和成纤维细胞(MUM1+、CD20+、CD27+、CD3+、COL1A1+、IgG+)(3)激活、常规 DCs 和巨噬细胞(HLA-DR、CD11c、CD1c、CD68、CD83)。对患者样本分析发现,表达 IgG 的 PC 与患者结果之间的关联表明抗肿瘤抗体的产生,这可能通过 DC 增加抗原呈递来改善 CD8 T 细胞反应。CD
技术资料暂无技术资料 索取技术资料










